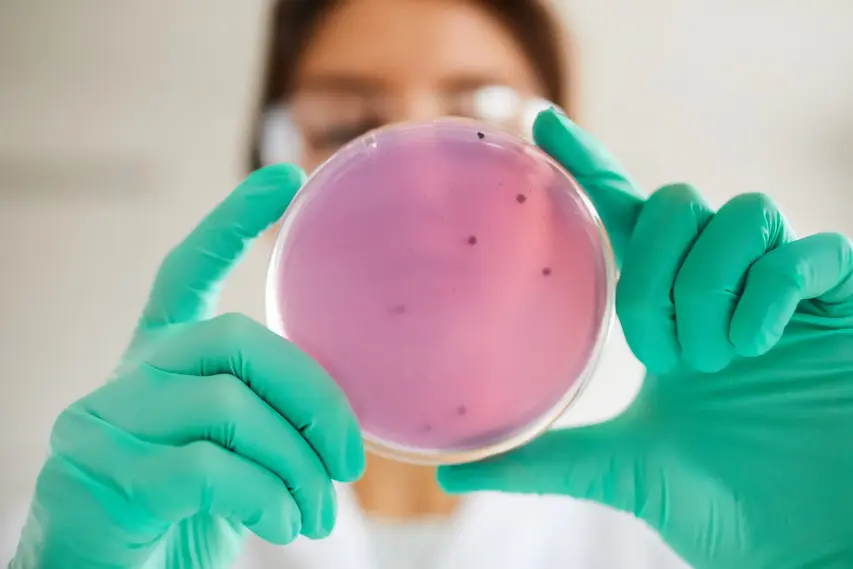
Microbiología

Banco de Sangre y Laboratorio Clínico
Servicios

Hematología y Coagulación
- Grupo sanguíneo
- Frote periférico
- Velocidad de eritrosedimentación (VS)
- Recuento de glóbulos blancos
- Hemoglobina
- Tiempos de Protrombina TP
- Tiempo Parcial de Tromboplastina TPT
- Dímero D
- Fibrinógeno

Química Clínica
- Glucosa
- Creatinina
- Perfil de Lípidos
- Pruebas Hepáticas
- Pruebas Renales
- Pruebas Cardíacas
- Ácido Úrico
- Colesterol
- Triglicéridos
- Hemoglobina Glicosilada

Inmunología y Serología
- Pruebas Tiroideas
- Prueba de Dengue
- Antígeno de Covid-19
- Proteína C Reactiva
- Factor Reumatoideo
- Prueba de Embarazo
- Hepatitis A, B y C
- Helicobacter pylori
- VIH

Orina y Heces
- Análisis de Orina completo
- Creatinina en orina
- Orina de 24 horas
- Proteínas totales en orina
- Microalbúmina
- Heces completo
Microbiología
- Urocultivo
- Cultivo de Garganta
- Cultivo de Heces
- Cultivo de Secreciones
- Hemocultivo
- Tinción de Gram

Banco de Sangre y Exámenes Especiales
- Células empacadas
- Plasma fresco congelado
- Plaquetas
- Marcadores tumorales
- Paneles de alergias
- Paneles por PCR
- Vitaminas
Exámenes Especiales
- Marcadores tumorales (PSA, CA-125, CA 19-9, AFP)
- Paneles de alergias (alimentos, inhalados, pediátrico)
- Vitamina D, Vitamina B12
- Hierro y Ácido fólico
- Insulina y Cortisol
- Gases arteriales y venosos
- Panel de drogas
- Panel gastrointestinal y respiratorio por PCR
¿Necesitas un examen específico?
Contáctanos o visítanos. Estamos disponibles 24 horas para atenderte.
Contáctenos

El Vital Servicio de Nuestro Banco de Sangre
En Alamoslab, nuestro Banco de Sangre es un pilar fundamental para la salud de nuestra comunidad. Operamos las 24 horas del día, los 365 días del año, proporcionando componentes sanguíneos seguros y de la más alta calidad a hospitales, clínicas y pacientes en toda Guatemala.
Cada donación de sangre es un acto de amor y solidaridad que puede salvar hasta tres vidas. Te ofrecemos un proceso de donación seguro, rápido y cómodo, guiado por nuestro personal altamente calificado.
Tu Confianza, Nuestra Prioridad
Nos dedicamos a la recolección, procesamiento y suministro de sangre y sus componentes con los más altos estándares de excelencia y confiabilidad. Tu salud y seguridad son nuestra razón de ser.
Tu Salud Integral en Alamoslab
Amplia Variedad de Exámenes en Nuestro Laboratorio Clínico para un Diagnóstico Preciso
En Alamoslab, entendemos que tu salud es lo más valioso. Por eso ofrecemos una gama completa de análisis clínicos que cubren todas tus necesidades de diagnóstico:
- Hematología y Coagulación: Hemogramas completos, tiempos de coagulación y más para evaluar tu sangre.
- Química Clínica: Glucosa, perfil de lípidos, función hepática y renal para un panorama completo de tu salud interna.
- Inmunología y Serología: Pruebas tiroideas, VIH, hepatitis y más para evaluar tu sistema inmunitario.
- Orina y Heces: Análisis completos para detectar infecciones, parásitos y problemas digestivos.
- Microbiología: Cultivos y antibiogramas para identificar infecciones y el tratamiento adecuado.
- Exámenes Especiales: Marcadores tumorales, paneles de alergias, vitaminas y pruebas moleculares PCR.
- Banco de Sangre: Componentes sanguíneos seguros disponibles las 24 horas.